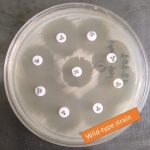
Wild type strains of bacteria

Collection Group: Clinical Bacteriology
Sodium Polyanethol Sulfonate : Introduction, Uses and Its Mode of Action
 Sodium Polyanethol Sulfonate Sodium polyanethol sulfonate is in brief SPS,...
Sodium Polyanethol Sulfonate Sodium polyanethol sulfonate is in brief SPS,...
Wild Type Strains: Introduction,Features and Related Terminology
Wild Type Strains Introduction Wild type strains are specific reference...
Wild Type Strains Introduction Wild type strains are specific reference...
Various Bacteria: Visible Growth and Their Identification
 Various bacteria in blood culture bottles showing their visible growth...
Various bacteria in blood culture bottles showing their visible growth...
